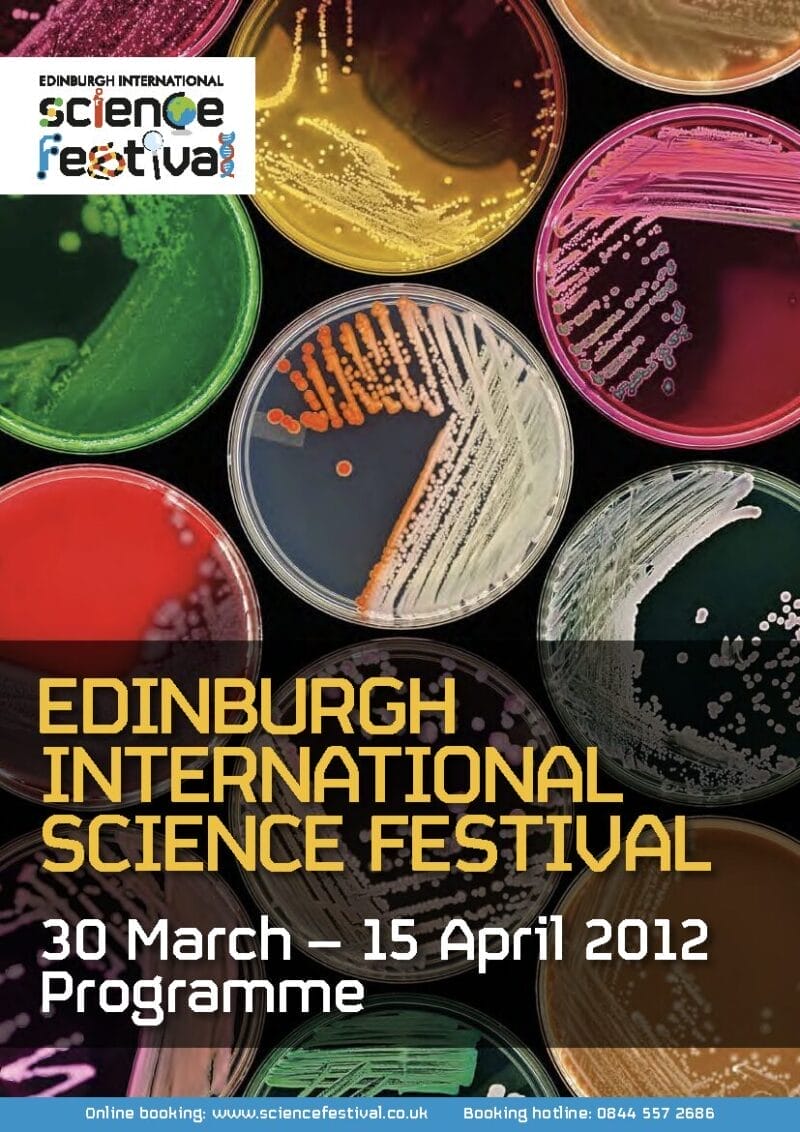

Download brochures from previous Festivals
Click below to explore the Festival programmes from each year back to 2012.
-

2026
-

2025
-

2024
-

2023
-

2022
-

2020
-

2019
-

2018
-

2017
-

2016
-

2015
-

2014
-

2013
-

2012